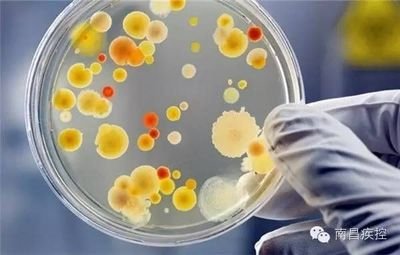

海鮮檢測機構可提供牡蠣檢測服務,檢測機構,目前國內的食品第三方檢測機構,可提供各類食品檢測,食品成分檢測,食品營養成分檢測,食品理化檢測,食品微生物檢測,食品衛生檢測等服務
2021-08-22
尼古丁成分含量去哪里檢測?檢測機構可提供尼古丁檢測服務尼古丁檢測范圍香煙尼古丁,血液尼古丁,煙草尼古丁,煙油尼古丁等。尼古丁檢測項目含量檢測,液相檢測,濃度檢測,成分檢測,成
2021-08-22
啤酒分析檢測去哪里?啤酒檢測報告去哪里辦理檢測方案齊全?檢測機構,酒類檢測中心可提供啤酒檢測服務,目前國內的食品第三方檢測機構,高新技術企業,CMA資質認證機構,可提供理化
2021-08-22
糧食檢測機構可提供黃豆檢測服務,中化所為CMA資質認證,擁有正規的食品實驗室,嚴格按照黃豆檢測標準進行實驗,任何關于食品檢測問題都可以聯系,可為您提供一站式服務。 檢
2021-08-22
桃膠檢測服務,包括桃膠膏,桃膠囊,冷凍桃膠,食用桃膠,燕桃膠等,第三方檢測機構,擁有正規的食品檢測實驗室,CMA資質證書,高新技術企業,可提供一站式檢測服務,檢測周期短、費用低、檢測數
2021-08-22
檢測中心-水果檢測機構可提供百香果檢測報告辦理服務,包括百香果籽,百香果果汁,百香果飲料,百香果奶茶,百香果果肉等。百香果檢測機構,擁有正規的食品實驗室,CMA資質證書,高新技
2021-08-22
霉變去哪里檢測?霉變檢測報告去哪里檢測認可度比較高?哪里有的檢測霉變機構?檢測機構可提供霉變檢測服務檢測周期:樣品測試周期一般為7-10個工作日。檢測費用:工程師根據檢測項
2021-08-22
去哪檢測食用菌?食用菌檢測去哪里認可度高?檢測機構可提供各種食用菌檢測服務,食品第三方檢測機構,擁有正規的食品檢測實驗室,檢測設備齊全,檢測團隊,CMA資質認證,高新技術企業
2021-08-22